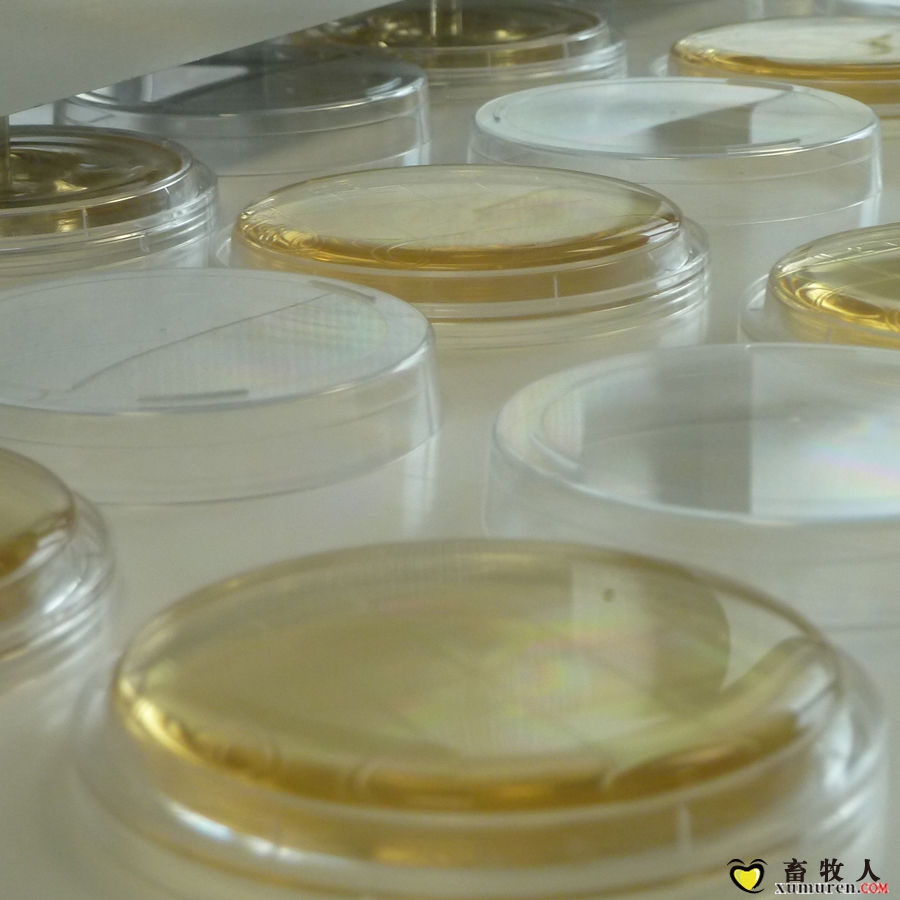

|
發(fā)布時(shí)間: 2017-7-25 08:58
正文摘要:培養(yǎng)基是液體、半固體或固體形式的,含天然或合成成分,用于保證微生物繁殖或保持其活力的物質(zhì)。培養(yǎng)基的制備和使用是微生物實(shí)驗(yàn)室檢測(cè)工作的重要環(huán)節(jié),培養(yǎng)基自身質(zhì)量的優(yōu)劣、保存是否得當(dāng)、配制使用是否正確等 ... |


畜牧人

畜牧人養(yǎng)豬
關(guān)于社區(qū)|廣告合作|聯(lián)系我們|幫助中心|小黑屋|手機(jī)版|
 京公網(wǎng)安備 11010802025824號(hào)
京公網(wǎng)安備 11010802025824號(hào)
北京宏牧偉業(yè)網(wǎng)絡(luò)科技有限公司 版權(quán)所有(京ICP備11016518號(hào)-1)
Powered by Discuz! X3.5 © 2001-2021 Comsenz Inc. GMT+8, 2025-11-23 12:53, 技術(shù)支持:溫州諸葛云網(wǎng)絡(luò)科技有限公司